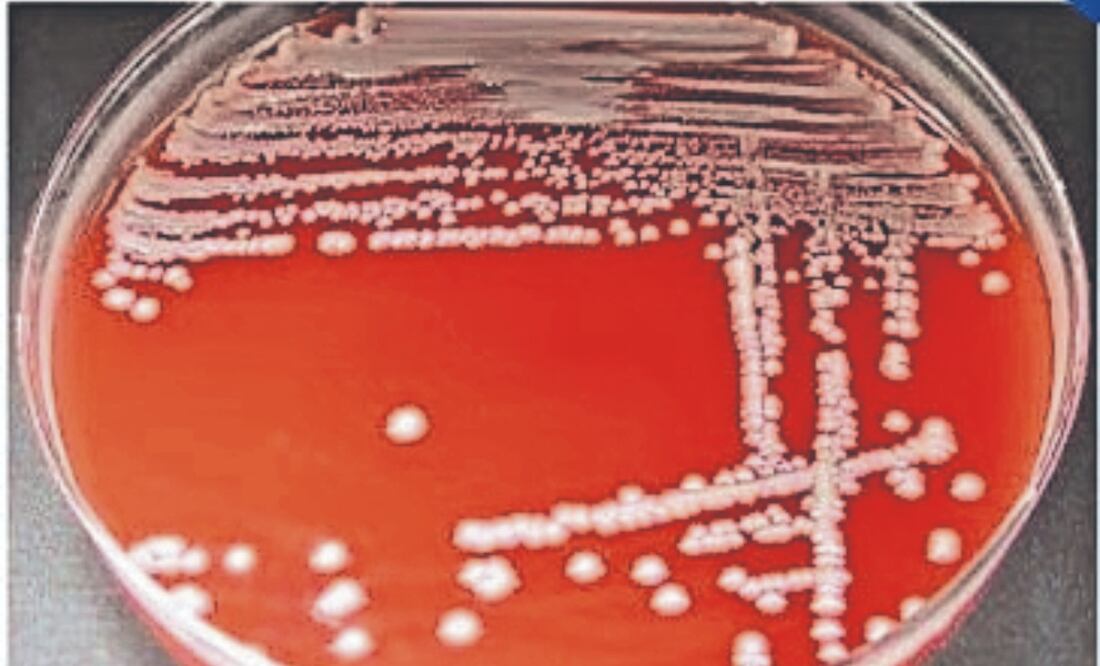
La bacteria, con forma de bastón, “se encuentra comúnmente en el tracto gastrointestinal de humanos y animales, así como en el medio ambiente”. Foto Especial

Más Información
Toluca, Méx.— La Secretaría de Salud federal tiene identificados 15 casos confirmados y cuatro probables, de la bacteria Klebsiella oxytoca, ubicados en tres unidades de salud públicas y una clínica privada, todos del Estado de México, por lo cual emitió una alerta epidemiológica la noche del martes 3 de diciembre.
Esta bacteria, con forma de bastón, “se encuentra comúnmente en el tracto gastrointestinal de humanos y animales, así como en el medio ambiente. Es una bacteria oportunista que puede causar infecciones en personas con sistemas inmunes debilitados”, detalló.
De acuerdo con la dependencia federal, el rango de edad de los casos confirmados es de cero a 14 años, aunque la mayor proporción corresponde a neonatos con administración de líquidos parenterales con datos clínicos y de laboratorio compatibles con infección del torrente sanguíneo (ITS).
La alerta epidemiológica emitida por la Secretaría de Salud Federal indica que el Brote de Infección del Torrente Sanguíneo por Klebsiella oxytoca relacionado a posible contaminación de Nutrición Parenteral (NPT) o insumos relacionados con su aplicación es “un problema de salud pública importante, principalmente en el ámbito hospitalario, debido a su frecuencia, gravedad y resistencia a los antibióticos, lo que hace que el tratamiento sea más difícil”.
Las enfermedades asociadas a esta bacteria son infecciones del tracto urinario, neumonía, infecciones de la piel y tejidos blan y sepsis.
De acuerdo con Mario Gutiérrez Arana, médico especialista de la Clínica Multidisciplinaria a la Salud de la Universidad Autónoma del Estado de México (UAEMex) esta bacteria comúnmente se encuentra en el tracto intestinal de humanos y animales; sin embargo, hoy ha sido identificada en la sangre, ahí el factor de riesgo.
Esto deriva, explicó, de contaminación en los insumos o el proceso de “nutrición parenteral”, es decir la acción de alimentación en pacientes que tienen dificultad para hacerlo vía oral, y por ello reciben suministros por vía intravenosa.
“Todavía no se ha establecido el origen de esta bacteria hay varias hipótesis como el material con el que se está realizando la conexión de la nutrición parenteral como una de las posibles causas de infección pero como tal todavía no hay información clara”, dijo.
Los síntomas en su caso se pueden relacionar con cualquier infección como: fiebre, taquicardia, disminución de plaquetas, o la aparición de moretones. Por el momento el riesgo para la población en su conjunto es mínimo, centrando el foco de atención en centros de salud y en sectores específicos.
“(...) Principalmente las personas que hayan recibido alguna nutrición parenteral del 18 de noviembre para acá principalmente neonatos hay que estar pendientes”, agregó el especialista. Con información de Miguel García
Noticias según tus intereses
[Publicidad]
[Publicidad]